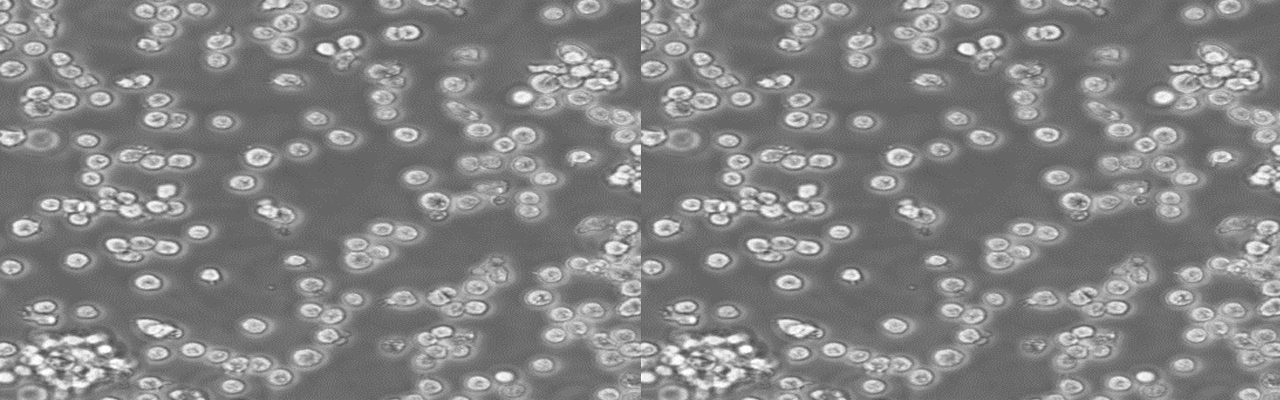

| 货号 | NCS-0617 |
| 名称 | CTLL-2 |
| 细胞全名 | 小鼠T淋巴细胞;CTLL-2 |
| 种属: | 小鼠 |
| 培养基: | RPMI1640+100U/mlrmIL-2(重组小鼠白介素-2)+10%FBS |
| 生长特性: | 贴壁生长 |
| 规格 | 1×10^6cells/T25培养瓶 |
| 支原体检测 | 阴性,见报告 |
背景资料:该细胞是源自C57BL/6的细胞毒性的T淋巴细胞。其生长以来IL-2。
仅供科研使用,不可用于临床诊断和治疗
冻存细胞接收后的处理:
1)干冰运输,收到细胞后立即转入液氮或直接复苏;
2)收到细胞后,若发现干冰已经完全挥发、冻存管瓶盖破裂脱落,请立即拍照后与我们联系。
复苏细胞接收后的处理:
1)收到细胞后,请首先检查培养瓶是否破损或漏液,培养液是否混浊,如有漏液及培养液混浊情况请立即拍照把图片发给我们。
2)75%酒精消毒瓶身后放培养箱中静置4-6h后,在显微镜下确认细胞状态并拍照100倍和200倍的照片,若有贴壁细胞脱落,可收集上清离心,将沉淀用新的培养基接种至新的培养瓶或培养皿中。
3)建议收到当天不要消化处理,如果细胞长满90%,可选择传代处理。
4)如您收到细胞3天内没有反馈相关问题,出现的细胞问题将不提供免费重发服务。
